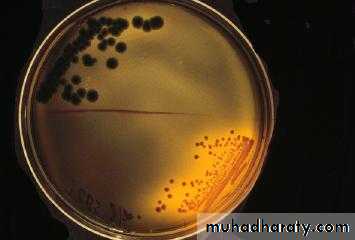

cholera
Cholera is a disease caused by infection with the gram-negative bacterium Vibrio cholerae.Only V. cholerae of the O1 and O139 serotypes are responsible for epidemic cholera in humans.
All other serotypes are generally grouped as "non-O1" strains; they are associated with sporadic cases of gastroenteritis but not with epidemic disease
The major virulence factor for V. cholerae O1 and O139 is cholera toxin,
. Binding of toxin to the surface of enterocytes leads to an elevation in cyclic AMP within the intestinal mucosa, causing an increase in chloride secretion, a reduction in sodium absorption, and the massive loss of fluid and electrolytes that produces the signs and symptoms of cholera gravis, or severe diseaseMost V. cholerae infections are asymptomatic,
The incubation period ranges from a few hours to five days, with most cases presenting within one to three daysSevere diarrhoea without abdominal pain followed by vomitting( Vomiting, frequently watery, is common, and may begin either before or after the onset of diarrhea).
Rice water diarrhoea
Dehydration and muscle grump due to electrolyte lose
Cont.
Low BP, decrease urine outputDeath and circulatory failure
Majority=== is Mild , subclinical , less diarhoea
Severe disease —(cholera sicca)
Cholera gravis is notable for how quickly a healthy adult can become severely ill.
Patients may present after only a few hours of illness with massive volume loss of between 500 and 1000 mL per hour, and rapidly can lose more than 10 percent of their body weight
Clinical diagnosis
Cholera should be considered in all cases of severe watery diarrhea and vomiting, especially those with rapid, severe dehydration.
Dehydrating diarrhea in children can be caused by many different microbial pathogens, but dehydration in an adult should lead to questioning about recent travel to Africa, Asia, or South and Central America, or ingestion of undercooked or raw shellfish
.
. However, there are no clinical features that can unequivocally distinguish cholera from other infectious causes of severe watery diarrhea, such as
enterotoxigenic Escherichia coli,
bacterial food poisoning,
or viral gastroenteritis
In adult :
volume depletion (which can cause renal failure)other common complications include potentially severe hypokalemia (which can cause arrhythmias, ileus, and, in combination with volume depletion, leg cramps) and metabolic acidosis.
hyperalbuminemia, or hyperphosphatemia resulting from acidemia-induced movement of phosphate out of the cells
Diagnosis Gram's stain of stools may show sheets of curved gram-negative rods,.Vibrios are often detected in the field by dark field or phase contrast microscopy of stool. Stool or rectal swabs are usually plated directly onto a selective medium . Antibodies to cholera toxin, which rise one to four weeks after infection and remain elevated, may also be diagnostic
TREATMENT
Oral rehydration — Oral rehydration solutions (ORS)
The WHO reduced osmolality solution contains, per liter of water2.6 g sodium chloride
2.9 g trisodium citrate
1.5 g potassium chloride
13.5 g glucose
Main lines of treatment
dehydration treated by:
Ringer's lactate.
Isotonic fluid
should be given at a rate of 20 mL/kg to a maximum of two liters every 15 to 30 minutes until peripheral perfusion improves and the heart rate returns to a normal range.
Metabolic acidosis and hypokalemia can be corrected by :
adding sodium and/or potassium bicarbonate to half-isotonic saline to create an isotonic solution.
Dextrose-containing solutions should not be used for volume repletion.
The presence of glucose or rice flour in the oral fluid has been shown to promote electrolyte absorption Chlorpromazine 50 mg 6-hourly reduces intestinal secretion and fluid loss
Antibiotic regimens for treatment of cholera according to age and the likelihood of tetracycline resistance
Tetracycline resistance Antibiotics Regimen Children Adults
Uncommon Doxycycline One dose 6 mg/kg (only if >age 8,) 300 mgTetracycline 4TD/ three day 12.5 mg/kg (only if >age 8) 500 mg
Erythromycin4TD/3D; children: 250 mg
Common
Azithromycin One dose 20 mg/kg to a maximum dose of 1000 mg
Ciprofloxacin One dose Not recommended 1000 mg
Norfloxacin Two times per day for three days Not recommended 400 mg
Thank
you
for
your
attention